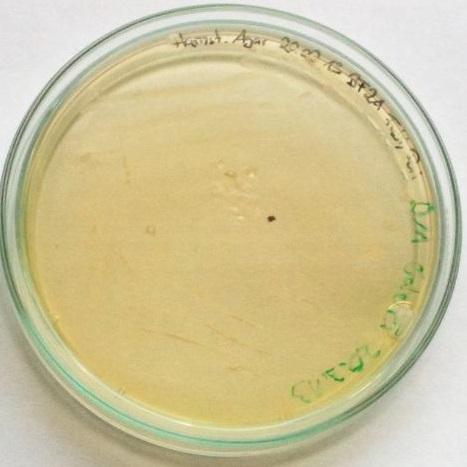

¿Qué es el caldo urea?
El caldo urea es un medio de cultivo líquido, utilizado para evidenciar la presencia de la enzima ureasa en ciertos microorganismos. La ureasa es una enzima microbiana que se produce de manera constitutiva, es decir, es sintetizada independientemente de estar o no presente el sustrato sobre el que actúa.
La función de la ureasa está relacionada con la descomposición de los compuestos orgánicos. No todos los microorganismos son capaces de sintetizar esta enzima, por tanto, su determinación en el laboratorio permite identificar ciertas cepas bacterianas, e inclusive diferenciar entre especies de un mismo género.
Existen dos tipos de prueba de la urea: Stuart y Christensen. Se diferencian en su composición y en la sensibilidad. La primera es especial para evidenciar gran cantidad de ureasa producida por especies del género Proteus.
La segunda es más sensible y puede detectar pequeñas cantidades de ureasa generadas tardíamente por otros géneros bacterianos, tales como Klebsiella, Enterobacter, Staphylococcus, Brucella, Bordetella, Bacillus, Micrococcus, Helicobacter y Mycobacterium.
El caldo urea de Stuart está compuesto por urea, cloruro de sodio, fosfato dipotásico, fosfato monopotásico, extracto de levaduras, rojo de fenol y agua destilada.
En tanto que el caldo o agar urea de Christensen está compuesto por peptonas, cloruro de sodio, fosfato monopotásico, glucosa, urea, rojo de fenol, agua destilada y agar-agar. Este último solo si se trata del medio sólido.
Fundamento
La enzima ureasa hidroliza la urea para formar anhídrido carbónico, agua y dos moléculas de amoníaco. Estos compuestos reaccionan para formar el producto final llamado carbonato de amonio.
Caldo urea de Stuart
El caldo urea de Stuart es más tamponado con un pH de 6,8. Por tanto, el microorganismo debe ser capaz de formar grandes cantidades de amonio para hacer virar al rojo de fenol. El pH debe elevarse por encima de 8.
Por ello, el caldo urea de Stuart es selectivo para especies de Proteus, dando resultados positivos en 24 a 48 horas de incubación, y no es efectivo para bacterias que producen pocas cantidades de ureasa o que hidrolizan lentamente la urea.
Esto se debe a que las especies de Proteus son capaces de utilizar la urea como fuente de nitrógeno. En cambio, otras bacterias productoras de ureasa necesitan una fuente adicional.
Sin embargo, Pérez y colaboradores concluyeron que el caldo urea de Stuart era tan eficiente como el agar urea de Christensen, para determinar la ureasa en cepas de levaduras de los géneros Candida, Cryptococcus, Rhodotorula, Trichosporon y Saccharomyces.
Los autores del estudio aseguran haber conseguido 100% de coincidencia con ambos medios (Stuart y Christensen) al incubar durante 24 y 48 horas, haciendo la salvedad de que tomaron como positivas las cepas que lograron virar los medios a un color rosado-fucsia fuerte.
Esta aclaratoria es necesaria, ya que Lodder afirmó que casi todas las levaduras logran colocar el bisel del agar urea de Christensen a rosado pálido. Esto es debido a que pueden hidrolizar la urea en mínimas cantidades, y a la formación de aminas por la descarboxilación oxidativa de los aminoácidos de la superficie. Esto no debe ser interpretado como positivo.
Caldo o agar urea de Christensen
El caldo o agar urea de Christensen es menos tamponado, siendo capaz de detectar pequeñas cantidades de amonio. Además, este medio está enriquecido con peptonas y glucosa. Estos compuestos hacen que se desarrollen otros microorganismos productores de ureasa que no crecen en el caldo Stuart.
Asimismo, la prueba de urea de Christensen ofrece resultados más rápidos, sobre todo para Proteus, pudiendo dar fuertemente positiva en tan solo 30 minutos como tiempo mínimo y hasta 6 horas como tiempo máximo.
El resto de los microorganismos productores de ureasa logran virar el color del medio levemente después de 6 horas, y fuertemente al cabo de 24, 48, 72 horas o más, e incluso algunas cepas pueden dar reacciones débiles después de 5 o 6 días.
Interpretación de ambos medios (Stuart y Christensen)
El medio originalmente es de color amarillo-anaranjado y una reacción positiva hará virar el color del medio a rosado-fucsia. La intensidad del color es directamente proporcional a la cantidad de amonio producido.
Una reacción negativa dejará el medio del color original a excepción de las levaduras, que pueden dar un rosado pálido con el medio agar urea de Christensen.
Preparación
Caldo urea de Stuart
Pesar los gramos necesarios según las indicaciones de la casa comercial. Disolver en agua destilada preferiblemente estéril. No usar calor para disolver, pues la urea es sensible al calor.
Para esterilizar se utiliza el método de filtración con membranas. Para ello se emplea un filtro Millipore con poros de 0,45 µ de diámetro. No utilizar autoclave. Una vez filtrada la solución, se distribuye en tubos estériles. Para obtener resultados confiables se debe trasvasar entre 1,5 ml como cantidad mínima a 3 ml como cantidad máxima por tubo.
Conservar en nevera y atemperar antes de usar.
Si no se dispone del método de filtración, el medio debe emplearse de forma inmediata para obtener resultados confiables.
Otra forma de preparar el caldo urea de Stuart es de la siguiente manera:
Algunas casas comerciales venden el medio base para la prueba de la urea, sin incluir la urea.
Se pesa la cantidad indicada por la casa comercial. Se disuelve en agua destilada y se esteriliza en el autoclave a 121 °C durante 15 minutos. Dejar reposar un poco y cuando el medio esté tibio se agregan 100 ml de una solución de urea preparada al 20% y esterilizada por filtración.
Se distribuye en tubos estériles, como fue descrito anteriormente.
Caldo o agar urea de Christensen
Preparación de la solución de urea
Pesar 29 g de urea deshidratada y disolver en 100 ml de agua destilada. Utilizar el método de filtración para esterilizar. No autoclavar.
Agar base de urea
Disolver 24 g del agar base deshidratado en 950 ml de agua destilada. Esterilizar en el autoclave a 121 °C por 15 minutos. Dejar reposar hasta que alcance una temperatura de 50 °C y agregar la urea anteriormente preparada de forma aséptica.
Verter 4 a 5 ml en tubos estériles e inclinar hasta que solidifiquen. Debe quedar un pico de flauta largo.
Este medio también se puede preparar de forma líquida.
Usos
- La prueba de la urea es extremadamente efectiva para distinguir el género Proteus de otros géneros de la familia Enterobacteriaceae, dada la rápida reacción que brinda Proteus.
- Si se usa la composición de Christensen, la prueba ayuda a diferenciar entre especies de un mismo género. Por ejemplo, S. haemolyticus y S. warneri son Staphylococcus coagulasa negativos y betahemolíticos, pero se diferencian en que S. haemolyticus es urea negativo y S. warneri es urea positivo.
- Por otra parte, McNulty empleó con éxito el caldo de urea de Christensen al 2% para estudiar la presencia de Helicobacter pylori en muestras de biopsias tomadas de la mucosa gástrica (región antral).
- La presencia de H. pylori se pone en evidencia con una prueba de urea positiva. El tiempo de duración para observar los resultados es directamente proporcional a la cantidad de microorganismos presentes.
- Como puede observarse, es un método sencillo para el diagnóstico de Helicobacter pylori en biopsias gástricas.
- Por último, esta prueba también es útil para diferenciar especies de los géneros Brucella, Bordetella, Bacillus, Micrococcus y Mycobacterias.
Sembrado de la prueba de urea
Los dos métodos requieren un inóculo microbiano fuerte para optimizar los resultados. Las colonias bacterianas se toman preferiblemente del agar sangre y las levaduras del agar Sabouraud, salvo algunas excepciones. El inóculo se emulsiona en el medio líquido.
Para el caldo urea de Stuart se incuba a 37 °C por 24 a 48 horas, sabiendo que solo se está en busca de cepas del género Proteus cuando la cepa es una bacteria. Para levaduras se puede incubar a 37 °C o a temperatura ambiente por 24 a 48 horas de incubación.
En el caso del caldo urea de Christensen se incuba a 37 °C por 24 horas. Si la prueba es negativa se puede incubar hasta por 6 días. Si la prueba da positiva antes de las 6 horas, indica que se trata de una cepa del género Proteus.
En el caso del agar urea de Christensen, se inocula fuertemente el bisel del agar, sin realizar punción. Se incuba e interpreta de la misma manera al caldo.
Control de calidad
Para probar el medio se pueden usar cepas controles, tales como Proteus mirabilis ATCC 43071, Klebsiella pneumoniae ATCC 7006003, Escherichia coli ATCC 25922 y Salmonella typhimurium. Las dos primeras deben dar resultados positivos y las dos últimas resultados negativos.
Referencias
- Christensen Medio (Urea agar base). Recuperado de britanialab.com.